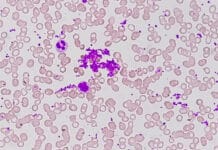
Persistent Gingival Bleeding Despite Excellent Home Care? What Dental Hygienists Should Know About Macrothrombocytopenia

If a child is not familiar with going to the dentist or unsure what treatments they will be subjected to, anxiety may arise but should mostly dissipate with age. When dental anxiety occurs in older teens, especially without a history of anxiety, there may be another problem that they are dealing with that we, and their guardians, may be unaware of.
Associations Between a History of Sexual Abuse and Dental Anxiety, Caries Experience and Oral Hygiene Status Among Adolescents in Sub-Urban Southwest Nigeria is a study conducted to determine if sexual abuse can lead to dental anxiety and a lack of self-care when it comes to dental hygiene.
Females, especially teenagers, in Nigeria have high rates of reported forced sexual encounters and, due to a lack of services and/or funds, and many are not seen by any type of health professional to help them deal with the physical and psychological repercussions of what happened. Certain tribal aspects of Nigerian culture can occasionally place shame upon the victim for what has happened and not the perpetrator, which stops victims from coming forward.
So, our question is: Can sexual assault decrease a person’s hygiene routine and increase their level of dental anxiety as a result of the abuse?
Sexual Assault Increases Dental Anxiety
We are trained to look for oral lesions and/or abnormalities during our examinations because many health problems, including STDs, have symptoms that occur in the oral cavity. This is usually something that is second nature, and we don’t think about it too much unless there is obvious proof that such a problem exists.
For example, physical damage from a forced sexual encounter can cause petechial hemorrhages at the meeting of the hard and soft palates. Besides physical damage and not knowing whether the child has been given an STD, forced sexual encounters can decimate their self-esteem and reduce their ability to build strong boundaries with their peers if they are not given appropriate psychological care to deal with what happened.
Usually, the best way to encourage our adolescent patients to stick with an effective oral hygiene routine is to concentrate on aesthetics since that is what most of them are preoccupied with at this age. When their sense of self-worth has been destroyed, and the shame they feel is not addressed, anxiety can occur in any situation where they are unsure of what will happen or know that they will be touched by another person and may somehow feel pain.
It is common for anyone who has suffered such abuse to neglect their body. They don’t want to be examined, prodded, questioned, or singled out for attention. This can cause even further damage and anxiety that will negatively affect their self-esteem, their personal routines, and their general mental health.
Sexual Assault Can Decrease OR Increase Dental Hygiene
The prevalence of sexual abuse on Nigerian adolescents did not appear to lead to a decrease in brushing and interdental cleaning. Still, it did increase the intake of alcohol, cigarettes, and illegal substances. The researchers cannot say, then, that their test subjects’ hygiene levels increased or decreased due to a lack of information that we generally receive from routine preventative care. This is because most dental care in Nigeria, where this research was done, isn’t preventative; it’s singular and curative.
We know that PTSD, substance abuse, unhealthy eating, and depression can all contribute to a decrease in an individual’s dental health in resource-rich areas, such as in the U.S. Still, many of us see the dentist routinely for preventative reasons. Unfortunately, this care is not always available in other countries. The children questioned in Nigeria didn’t have a prior relationship with a dental team, so there was no history of their dental care and recent status.
Such abuse has also been known to cause obsessive-compulsive behaviors in both adults and adolescents who reportedly ‘feel dirty,’ so they over-brush and over-floss, which can cause oral damage, sometimes to the extreme. Without the needed routine care, these patients may accidentally cause harm to their teeth and gingiva, for example, increasing tooth and periodontal infections.
As dental health professionals in a ‘first-world’ setting, we have the ability to monitor our patients’ dental care routinely, but we also get to know them in a way that allows us to notice if something has changed when they are in the dental chair. Has their behavior changed noticeably? Do they seem more anxious? Unless our patients offer up such personal information, we won’t know if they have suffered such abuse. But we can ask our patients how they feel and how their lives have been going. We can show them that we do care.
This is extremely important with our younger patients who may not understand what they have suffered and how they feel.
So, it is our job to observe the state of their mouths and note any changes in their demeanor. Our job is more than just teeth and gingiva. Keep your eye out for damaged tissue and other signs of sexual abuse. Maintain your checks for STD symptoms and oral abnormalities and really get to know your patients. This can make all the difference.